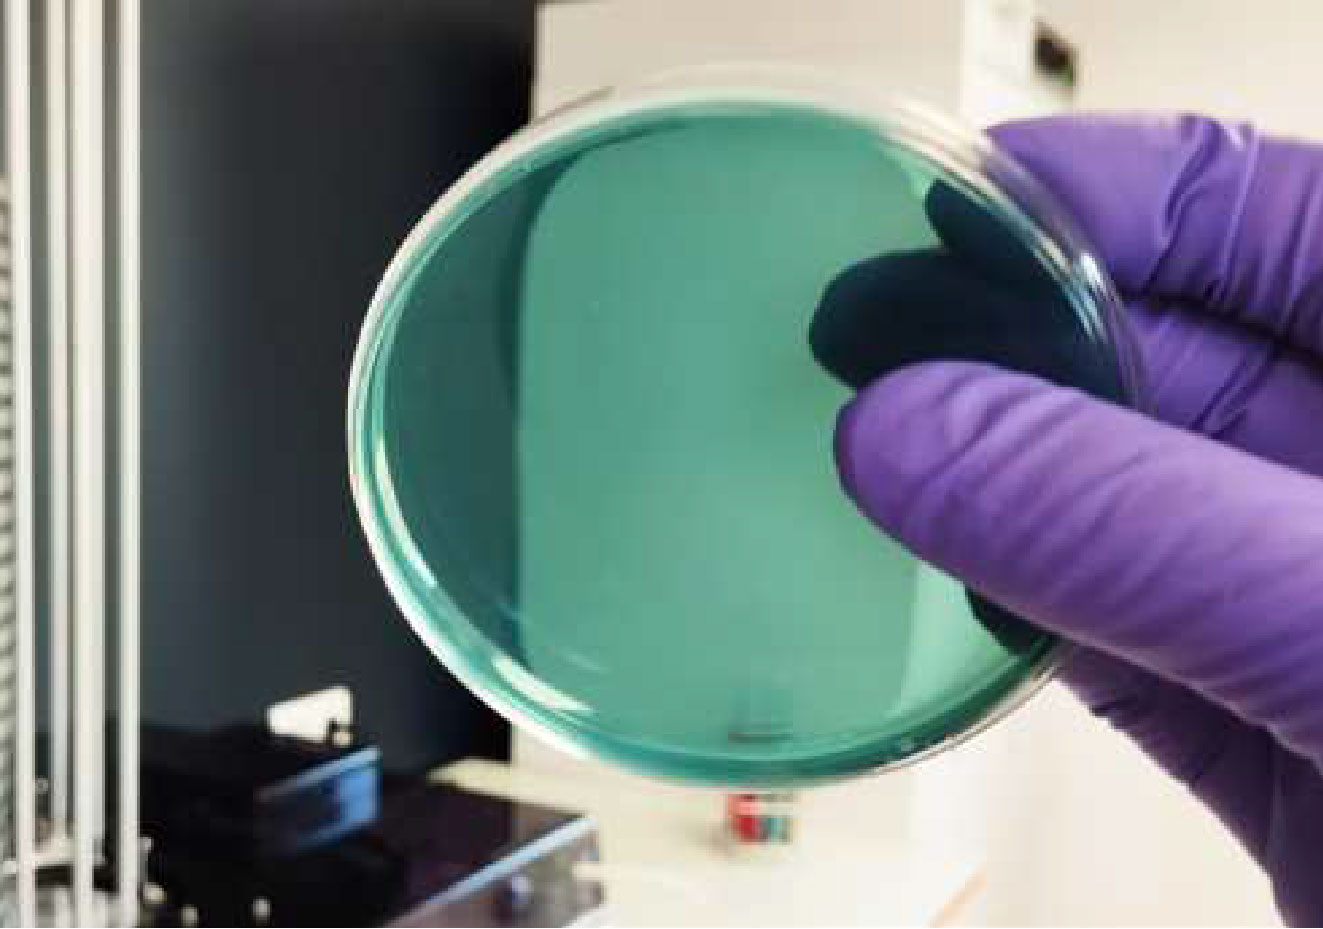

DISTRIWEL 440
卓越效能,專為高通量設計
• 真正免看管作業:30 分鐘快速完成 440 個培養皿
• 穩定的 ±1 mL 分注精準度,確保每一皿品質一致
• 高速生產能力,輕鬆應對大量製備需求
• 穩定的 ±1 mL 分注精準度,確保每一皿品質一致
• 高速生產能力,輕鬆應對大量製備需求
更快、更穩定的培地品質
• 內建 Peltier 冷卻技術,有效減少凝結水並加速凝固
• 支援主流培養皿尺寸 55mm / 90mm,使用更彈性
• 支援主流培養皿尺寸 55mm / 90mm,使用更彈性
多樣化功能延伸(選配)
• 線上血液添加功能,節省手動混合時間
• Plate Pouring 系統,免除傳統手動分散動作,提升一致性
• Plate Pouring 系統,免除傳統手動分散動作,提升一致性
![]() |
大幅提升生產效率 30 分鐘即可完成 440 個培養皿灌注。 全程自動化,真正的 免看管作業,節省人力與時間。 |
![]() |
更佳的培養品質 藉由 Peltier 效應有效控制凝固過程,並減少冷凝現象。 |
![]() |
Plate Pouring 模式,無需手動搖動 選配自動 Plate Pouring 功能,告別繁瑣的手動「8 字形」分散動作。 |
![]() |
更安全的微生物操作環境 UV 殺菌與透明護罩雙重設計,降低操作過程中的汙染風險。 |
![]() |
直覺式觸控螢幕 搭載專為微生物實驗設計的操作系統。 反應快速、介面直觀,可立即存取各項程式。 |
![]() |
噴墨列印功能(選配) 使用 LINX8900,可在培養皿側邊印製最多 15 字元(2行),便於追蹤與標識。 |
|
Petri dishes per hour
|
Up to 880
|
|
Distribution modes
|
Automatic with carrousel and manual
|
|
Capacity
|
440 Petri dishes
|
|
Fast cooling
|
Built-in Peltier effect
|
|
Contamination prevention
|
Built-in UV lamp
|
|
Distribution speed
|
From 30 to 300 RPM
|
|
Distribution accuracy
|
± 1ml
|
|
Distribution volume
|
1 - 99ml
|
|
Stack plates function
|
✓
|
|
Peristaltic pump
|
Integrated pump (double pump in option)
|
|
Programs
|
50
|
|
Touchscreen
|
Tactile, LCD 7’’
|
|
Traceability
|
Ink jet printer on the Petri dish sides (also possible from the bottom of the dish, on demand)
|
|
USB
|
✓
|
|
Ethernet
|
✓
|
|
Footswitch (for manual distribution)
|
✓ (option)
|
|
Dimensions (L x l x H)
|
689 x 808 x 940 mm
|
|
Weight
|
48 kg
|
|
Power supply
|
115 or 230V ±10% - 50/60Hz - 3A max - 150W
|
|
Country of origin
|
France - European Union
|
|
Warranty
|
1 year
|
|
DISW1001P
|
Distriwel with blood addition kit
|
|
DISW1001X
|
Distriwel with LINX printer kit
|
|
DISW1001XP
|
Distriwel with blood addition + LINX printer kit
|
|
DISW1001S
|
Distriwel with plate pouring system
|